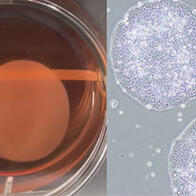
iPS细胞再生医疗产品在日本首次获批，心力衰竭等疾病的治疗选择将增加

日本大阪大学等组成的研究团队通过小鼠实验,证实了类风湿关节炎等自身免疫性疾病在寒冷环境中症状发生变化的部分机制。研究发现一种名为“信号素6D(Semaphorin 6D)”的血管内皮细胞蛋白,能够调控交感神经,进而对免疫功能产生影响。这一发现有望推动关于外界气温与免疫反应关系的全新研究。

大阪大学吹田校区(大阪府吹田市)
已知类风湿关节炎、多发性硬化症等自身免疫性疾病,在气温较低的环境下症状会恶化。然而,寒冷环境与免疫系统之间的关联此前一直不清楚。
大阪大学的水野裕美子特任助教、熊之乡淳校长等人,将研究焦点放在了血管内皮细胞的信号素6D上,对无法产生信号素6D的小鼠与普通小鼠进行了对比。结果显示,无法产生信号素6D的小鼠,其交感神经会出现过度激活,在寒冷环境下神经递质“去甲肾上腺素”的含量会增加。
另外,在使用被诱导出现自身免疫疾病“麻痹”症状的小鼠进行的实验中,无法产生信号素6D的小鼠在寒冷环境下免疫细胞的功能较弱,麻痹的程度也更轻。在常温环境下,两者的麻痹程度无明显差异。这表明信号素6D可能与寒冷环境下的免疫功能有关。
今后,研究团队将结合一天内气温及日照变化等因素开展进一步研究,阐明更详细的机制。汇总相关研究成果的论文已发表在学术期刊《The Journal of Immunology》上。
原文:《日本经济新闻》、2026/3/31
翻译:JST客观日本编辑部
【论文信息】
期刊:The Journal of Immunology
论文:Endothelial semaphorin 6D controls immune responses under cold stress through regulation of sympathetic innervation
DOI:doi.org/10.1093/jimmun/vkaf362